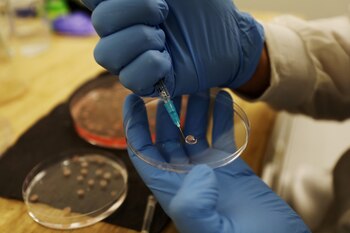
La medicina está avanzando sobre

La medicina está viviendo un momento inédito y revolucionario en pos de la prevención y tratamiento de distintas enfermedades que hasta ahora no han tenido una respuesta clara y efectiva para millones de pacientes que las padecen todos los años.
Durante las últimas tres décadas, los científicos avanzaron en la investigación de vacunas contra el cáncer para personas sanas con alto riesgo de padecerlos, pero se encontraron diferentes barreras para su desarrollo.
La actual medicina moderna profundizó la idea de base para enfrentar distintas enfermedades como el cáncer y otras más bajo la consigna de que cualquier célula maligna incipiente podría ser eliminada por el sistema inmunitario. Ese acercamiento no sería diferente al modo en que las vacunas hoy protegen contra las enfermedades infecciosas. En la actualidad, hay ensayos en marcha sobre vacunas para cáncer de páncreas, cáncer de colon y de mama.

Concretamente respecto al cáncer de páncreas, una enfermedad que pese a no ser uno de los más frecuentes en cuanto diagnóstico, es el que presenta la tasa más baja de supervivencia en todo el mundo, ayer se anunció una importante novedad.
En pos de prevenir a este llamado “asesino silencioso”, ya que el comienzo de la enfermedad es difícil de identificar, la medicina ha logrado desarrollar una vacuna experimental de ARN mensajero personalizada, que ha conseguido resultados “prometedores” contra el cáncer de páncreas en la Fase I de un estudio clínico.
Así lo ha revelado un artículo publicado en la revista Nature y liderado por investigadores del Memorial Sloan Kettering Cancer Center (Estados Unidos) en la que se destaca que los primeros resultados de un ensayo clínico con 16 voluntarios ha demostrado que la vacuna induce una respuesta inmunitaria sustancial y retrasa potencialmente la recaída de los pacientes en una forma de cáncer de páncreas, concretamente, el adenocarcinoma pancreático ductal, que es uno de los tumores con tasas de supervivencias más bajas.

El adenocarcinoma ductal pancreático es letal en el 88% de los pacientes, sin embargo, alberga neoantígenos de células T, unas proteínas que pueden surgir en la superficie de los tumores tras ciertos tipos de mutaciones del ADN y que son adecuadas para vacunas.
Los expertos del Centro de Cáncer Memorial Sloan Kettering de Nueva York (Estados Unidos) se preguntaban por qué existe un 12% de los afectados que logra superar esta patología. La razón estaba centrada en los linfocitos T, los cuales, al igual que ocurre con otros tumores, evidenciaron una respuesta inmune de hasta 12 veces superior que aquellos que integran ese fatídico 88%.
En combinación con quimioterapia e inmunoterapia, los investigadores han descubierto que la vacuna personalizada de ARN mensajero preparada según las características del tumor de cada paciente provocó respuestas sustanciales de células T en el 50% de ellos.

“Se observaron respuestas inmunes sustanciales de linfocitos T en el 50% de los voluntarios, lo que indica que la vacuna puede inducir una respuesta inmunitaria mejorada”, señalaron los investigadores. Pero además, lograron identificar que se elevó la cantidad de “linfocitos asesinos” en el organismo de los pacientes, lo cual podría provocar una ausencia de recaídas.
“El cáncer de páncreas es uno de los más mortales, con una supervivencia a 5 años de menos del 10 %; y eso no ha cambiado en varias décadas. Es la causa de aproximadamente 50.000 muertes en los Estados Unidos cada año, que ocupa el tercer lugar después del cáncer de pulmón y colon. Los pacientes con cáncer de páncreas típicamente se presentan tarde en su curso, cuando hay neoplasias intraepiteliales de alto grado (PanIN) o adenocarcinoma invasivo, junto con las alteraciones genéticas características”, sostuvo el reconocido científico Eric Topol, director del Instituto de Investigación Traslacional, en California, Estados Unidos.
“Una revisión en The Lancet enfatizó que se necesitan desesperadamente nuevas estrategias para evaluar a pacientes de alto riesgo para detectar tumores pancreáticos en etapas más tempranas para lograr un impacto clínicamente significativo”, agregó el experto que no dudó en destacar la noticia de la nueva vacuna como “un doble golpe contra el cáncer de páncreas”.
Técnica del ARN mensajero
Las vacunas ARNm pusieron coto al COVID-19, una tecnología que, sin embargo, fue concebida inicialmente para intentar desarrollar vacunas contra el cáncer. Se trata de un fértil campo de investigación gracias al mejor conocimiento del sistema inmune y los desarrollos técnicos.
Otra de las voces más reconocidas a nivel científico en sus avances con el ARN mensajero es la doctora Katalin Karikó, bioquímica y profesora adjunta de la Escuela de Medicina Perelman de la Universidad de Pensilvania, Estados Unidos de América, que fue premiada por L´Oreal -Unesco Por las mujeres en la ciencia -edición 2022- en la categoría Laureates por su innovador desarrollo de un ARN mensajero no inflamatorio, que puede ser una vacuna potente contra COVID y también contra distintos tipos de cánceres.
Infobae entrevistó a Karikó en París, donde recibió el galardón. Y allí, la vicepresidente senior de BioNTech RNA Pharmaceuticals afirmó: “Quiero centrarme en hacer una ARN que codifique proteínas terapéuticas, que ayude curar heridas, sanar huesos y que ayude a curar pacientes con cáncer”. “El nuevo capítulo en medicina es que el paciente generará la proteína por sí mismo. Serán moléculas que instruyen a las células para más adelante fabricar las proteínas terapéuticas por sí mismas contra distintas enfermedades. Lo más importante es que será un tratamiento asequible porque será barato de hacer, sin demasiados efectos secundarios”, afirmó Karikó.

Una media de supervivencia más elevada
La nueva vacuna experimental anunciada ayer es un paso revolucionario en la medicina. Las pruebas, luego de su aplicación han sido seguidas durante 18 meses en los pacientes con células T expandidas, obteniendo una media de supervivencia libre más larga en comparación con los pacientes sin células T expandidas por la vacuna (13,4 meses).
Para los expertos, esos resultados demuestran el potencial de las vacunas individualizadas de ARN mensajero en el tratamiento de este cáncer de páncreas, además de aportar pruebas de su eficacia general como herramienta terapéutica en el tratamiento de la enfermedad.
Los autores del estudio científico han señalado que, a pesar del tamaño limitado de la muestra, estos primeros resultados indican que está justificado realizar estudios más amplios de este tipo de preparados. Para el jefe del Servicio de Inmunología en el Hospital Clínic de Barcelona, Manel Juan, “el estudio está muy bien diseñado y su calidad científica es indudable”.
“Demuestra algo que ya ha sido sugerido antes muchas veces (con datos menos sólidos), como es que la vacunación personalizada con ARNm de antígenos tumorales es eficaz en inducir una respuesta y que puede, como mínimo, incrementar los períodos de supervivencia”, según afirmó este investigador, que no participó en el trabajo.

Estos resultados demuestran el potencial de las vacunas individualizadas de ARNm en el tratamiento de este tumor, además de aportar pruebas de su eficacia general como herramienta terapéutica en el tratamiento de la enfermedad. Los autores señalan que, a pesar del tamaño limitado de la muestra, estos primeros resultados indican que está justificado realizar estudios más amplios de este tipo de vacunas para el cáncer de páncreas.
Este ensayo ha dado lugar a otro en fase 2, ya en marcha y en el que participan varios centros españoles, entre ellos el que coordina Ignacio Melero, catedrático de Inmunología de la Universidad de Navarra, investigador del CIMA y codirector del departamento de Inmunología e Inmunoterapia de la Clínica Universidad de Navarra.
“Las vacunas ARNm personalizadas combinadas con inmunomodulación son claras candidatas a dominar los tratamientos en oncología, sobre todo aplicadas alrededor de la cirugía con intención curativa”, concluyó Melero.
Seguir leyendo
Últimas Noticias
Descubren que un marcador sanguíneo del Alzheimer ayuda a detectar enfermedades cardíacas y renales
Una proteína clave mostró un inesperado comportamiento en el organismo, abriendo nuevos caminos para comprender daños en órganos más allá del cerebro

Avances ante enfermedades y uso de fármacos: así es el microscopio que permite la observación de células vivas en tiempo real
El instrumento desarrollado en Stanford permite visualizar procesos biológicos minuciosos y detectar alteraciones en organismos vivos, aportando información valiosa para comprender la respuesta frente a agentes externos

Enfermedad renal: los avances terapéuticos y el diagnóstico temprano son clave para prevenir complicaciones
En los últimos años, especialistas en nefrología destacan que la introducción de tratamientos innovadores y la identificación precoz de alteraciones en la función renal han transformado el abordaje. Los factores de riesgo

Por qué el cerebro responde con más velocidad ante buenas noticias inesperadas, según la ciencia
Un estudio de la University of Colorado Boulder muestra que la sorpresa positiva estimula la dopamina y eleva la rapidez de los movimientos en apenas 220 milisegundos, abriendo nuevas posibilidades para monitorear trastornos neurológicos

Un asteroide recién descubierto por la NASA pasará cerca de la Tierra esta noche
Astrónomos internacionales observarán el paso del objeto identificado como 2026 EG1, que tiene el tamaño de un autobús. Aclararon que no implica un riesgo de choque


